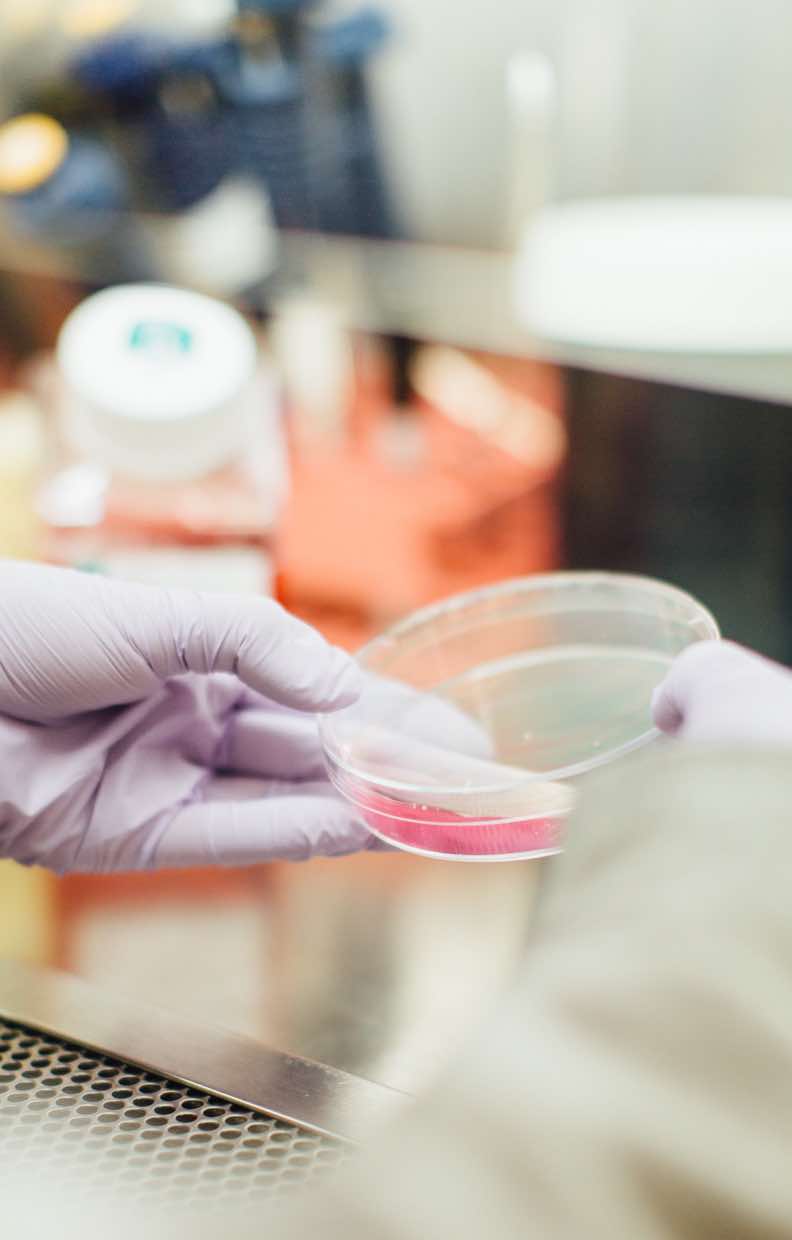

Start your
career & pursue
your passion
Our student
body is diverse
and inclusive
Alyssa Watson
BA Business Management / Digital Marketing Executive
Everything that I learned at Kempbelle University really helped put me above the competition in the field of business management.
About the University
At Estuidar University, we prepare you to launch your career by providing a supportive, creative, and professional environment from which to learn practical skills, build a network of industry contacts, and gain real-world experience. You’ll have the opportunity to generate innovative design and business solutions.
of recent graduates
started new job
degree programs
years of history
Campus Information
At Estuidar University, we prepare you to launch your career by providing a supportive, creative, and professional environment from which to learn practical skills, build a network of industry contacts.
Graduate Programs
At Estudiar University, we prepare you to launch your career by providing a supportive, creative, and professional environment from which to learn practical skills, build a network of industry contacts, and gain real-world experience.
We’re now eleven years into our experiment and incredibly proud of the outcome. We’ve educated over 875 students between 2009-2020 through in-person programs.
In the lab, you will have an opportunity to analyze samples on each instrument, and carry out an independent project where you analyze a sample of your own choosing.
- Sciences

This new plan is designed to reduce the average cost of a Make School Education while preserving the core protections of ISAs
- Management

The Economics Major can be combined with a Major in another subject in order to create an Honors Double Major Degree.
- Economics

In biochemistry courses, you will study the structure, properties, and reactivity of molecules in living organisms.
- Sciences

We prepare you to launch your career by providing a supportive, creative, and professional environment
- Business & Administration

A d m i s s i o n & A i d
At Estuidar University, we prepare you to launch your career by providing a supportive, creative, and professional environment from which to learn practical skills, build a network of industry contacts.
How to Apply
- You Apply
Tell us a little about yourself and we’ll help with the rest. Our convenient online application tool only takes 10 minutes to complete.
- We Connect
After you submit your application, an admissions representative will contact you and will help you to complete the process.
- You Get Ready
Once you’ve completed your application and connected with an admissions representative, you’re ready to create your schedule.
Scholarship Programs
At Estuidar University, we prepare you to launch your career by providing a supportive, creative, and professional environment from which to learn practical skills and build a network of industry contacts.
Tuition & Fees
This new plan is designed to reduce the average cost of a Make School Education while preserving the core protections of ISAs – if you don’t have a job after Make School, you should not have to pay until you are employed.
Tuition Costs,
2020-2022
-
Fall 2020 $15,000
-
Spring 2021 $15,000
-
Summer 2021 $10,000
-
Fall 2021 $15,000
-
Spring 2022 $15,000
total
$ 75,000
Tuition Costs,
2021-2023
-
Fall 2021 $10,000
-
Spring 2021 $10,000
-
Summer 2022 $15,000
-
Fall 2022 $25,000
-
Spring 2023 $25,000
total
$ 85,000
CENTER OF EXCELLENCE IN
THE NORTH EAST
Student
Life
Our students create a vibrant and inclusive community
The Campus
Experience
At Estuidar University, we prepare you to launch your career by providing a supportive, creative, and professional environment from which to learn practical skills, build a network of industry contacts, and gain real-world experience. You’ll have the opportunity to generate innovative design and business solutions.
News & Events
USTM holds Health Camp at Old Age Home
9th Mile, Khanapara, Ri Bhoi, May 19, 2023 A day-long outreach programme on “Enhancing Wellbeing: Charitable Support and Health Assessments for Senior
Workshop held on “Telecommunication & Quality Services”
World Telecommunication & Information Society Day The “World Telecommunication & Information Society Day, 2023” was observed here today by the Department of
International Day of Light celebrated by USTM
Capacity Building Workshop on Distance Learning A workshop on “Solar Astrophysics: A quality approach to Solar Research” and a quiz competition have